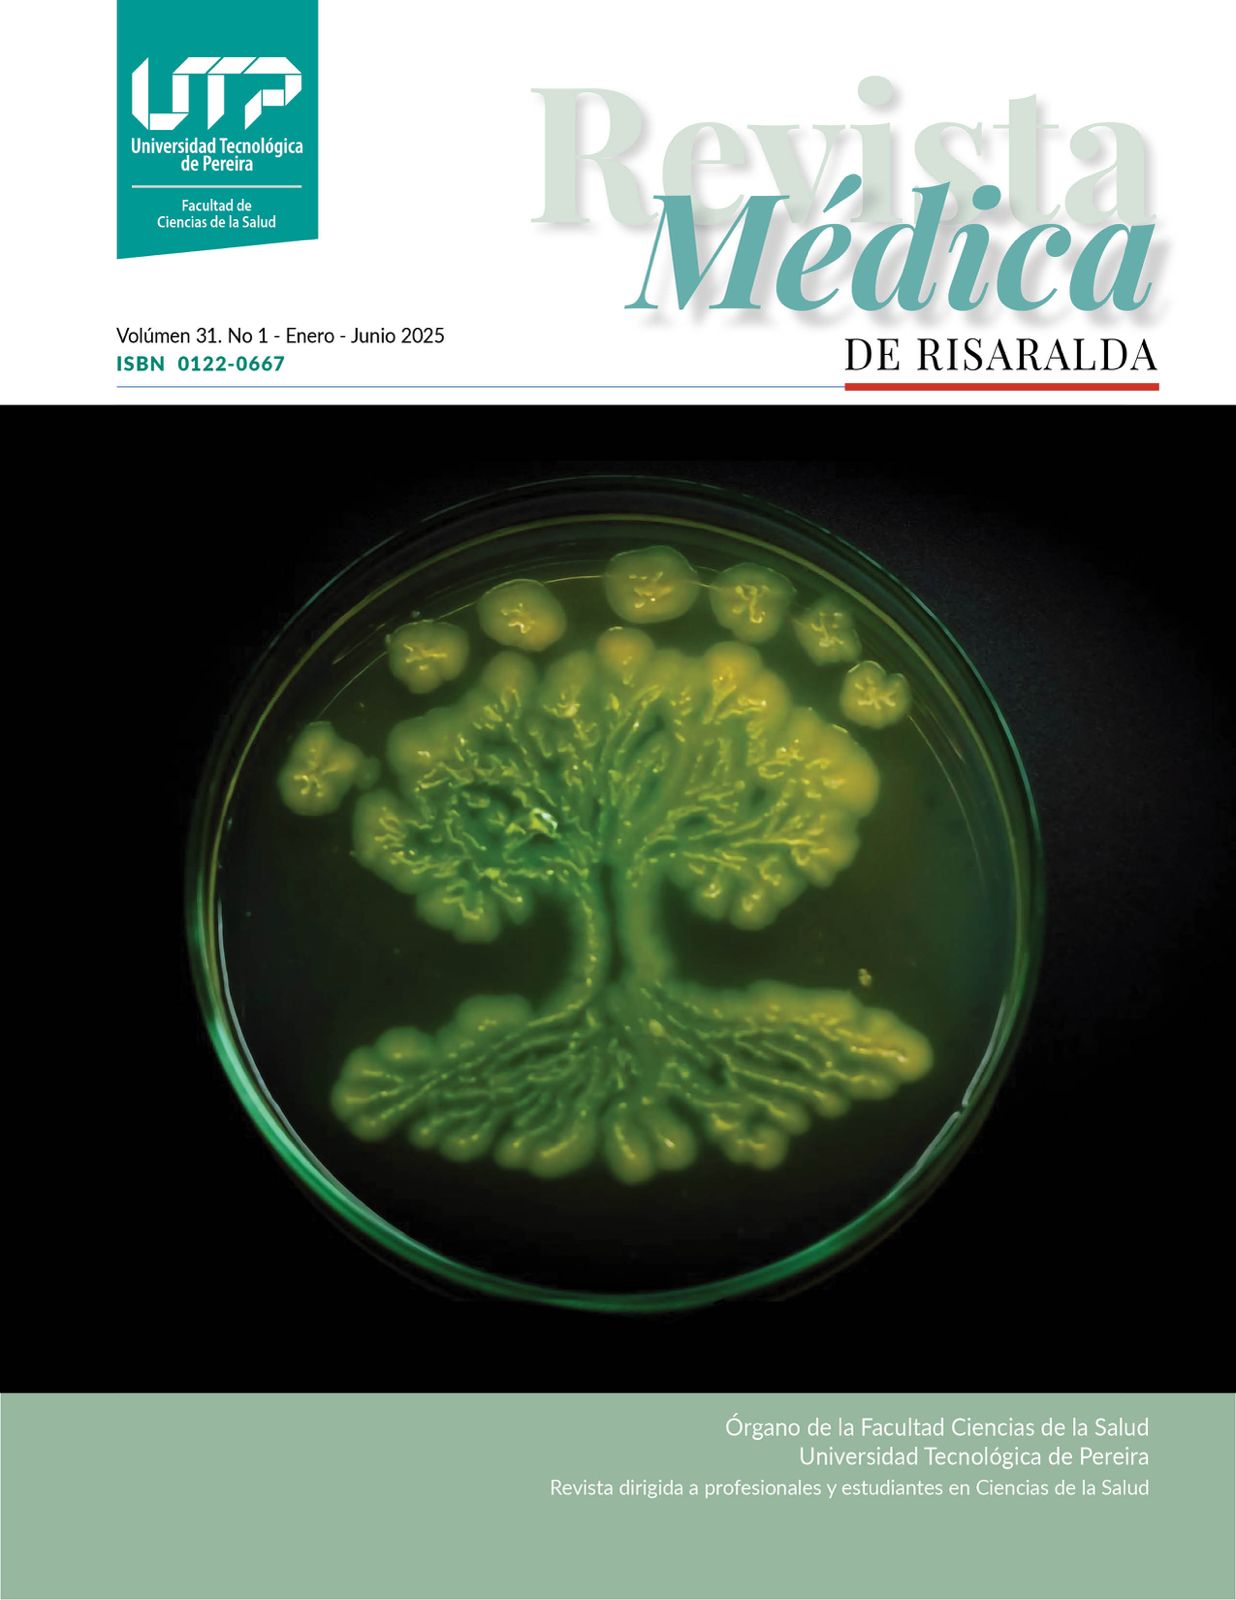

- Inicio
- Acerca de
- Directorio
- Artículos
- Cómo publicar
-
Política editorial
- Política de evaluación por pares
- Política de secciones
- Política de acceso abierto
- Política antiplagio
- Política de autoarchivo
- Política de conflictos de intereses
- Política de publicidad
- Política de preservación digital
- Política de supervisión ética
- Política sobre el uso de la inteligencia artificial
- Política de buenas prácticas editoriales en igualdad de género
- Índice
- Estadísticas
- Avisos
- Inicio
- Acerca de
- Directorio
- Artículos
- Cómo publicar
-
Política editorial
- Política de evaluación por pares
- Política de secciones
- Política de acceso abierto
- Política antiplagio
- Política de autoarchivo
- Política de conflictos de intereses
- Política de publicidad
- Política de preservación digital
- Política de supervisión ética
- Política sobre el uso de la inteligencia artificial
- Política de buenas prácticas editoriales en igualdad de género
- Índice
- Estadísticas
- Avisos